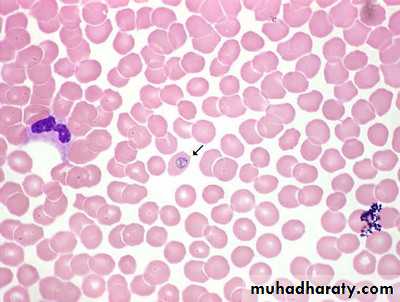

Malaria
Instructional Objectives:At the end of the lecture the student would be able to:1-Demonstrate the main clinical characteristics of Malaria and Bilharziasis.2-Point out the occurrence of the disease.3-List the causative agent, mode of transmission, incubation period, and period of communicability of Malaria and Bilharziasis.4-List the main preventive measures of Malaria and Bilharziasis.5-Describe the control measures of Malaria and Bilharziasis.
Parasitic infectious disease with four human species that have similar clinical symptoms to be differentiated through laboratory.
Fever pattern during the first few days is similar to early stages of other bacterial, viral, or parasitic illness.
*Malignant tertian or falciparum malaria is the most serious.
It may present with fever, chills, headache, sweats, cough, diarrhea, respiratory distress, jaundice, coagulation defects, shock, renal and hepatic failure, acute encephalopathy, pulmonary and cerebral edema ,coma and death.Case fatality rate is (10- 40 %) or higher .
*Other human malarias (Vivax, malaria, ovale) are generally not life threatening.Usually it presented with malaise, slowly rising fever over several days followed by shaking, chills and rapidly rising temperature associated with headache, nausea, and end by profuse sweating.
After an interval free of fever, the cycle of chills, fever, and sweating is repeated either daily, every other day or every third day.
Infectious Agents
Plasmodium vivax benign tertian malaria.Plasmodium malariae quartan malaria.
Plasmodium falciparum malignant tertian malaria.
Plasmodium ovale.
*Mixed infectious can occur in endemic areas.
Occurrence:
*Endemic malaria is a major cause for ill health in many tropical and subtropical areas.*It causes one million deaths per year in Africa , mostly in children.
Reservoir:
*Humans are the only important reservoir of human malaria.
Mode of transmission :
A/ Congenital transmission occurs rarely.However still birth from infected mothers is more frequent.
B/Bite of infective female anopheles mosquito.
C/Injection or transfusion of blood from infected person.
D/Use of contaminated needles and syringes.
Prepatent period :
It is the period between the infective bite and the detection of parasite in thick blood smear.It is usually (6-12) days in falciparum.
(8-12) days in vivax and ovale .
(12-16) days in malariae.
Incubation period :
A/Through bite of mosquito :(9-14) days for falciparum.
(12-14) days for vivax and ovale .
(18-40) days for malaria.
B/Through blood transfusion : usually short incubation period .
It depend upon the number of parasites infused.
Prolonged incubation period occurs by drug suppression such as prophylaxis.
Period of communicability:
*Untreated or insufficiently treated patients are considered the main source of mosquito infection .( many years)*Mosquito remains infective for life.
*Stored infected blood remains infective for one month.Susceptibility & Resistance:
*Universal susceptibility except certain specific traits.*Tolerance to clinical disease is present among adults in highly endemic areas.
*Black Africans show natural resistance to vivax.
*Sickle cell trait relative low parsitemia in falciparum might lead to a relative protection from sever disease.
Preventive Measures
• Community Based Measures :• 1.Insecticide treated Mosquito nets (most useful).
• 2.Indoor residual spraying with insecticides.
• 3.Control of larval stages by elimination of mosquito breeding sites (increasing the speed of water)
• 4.Intermittent preventive treatment with full curative dose of antimalarial drug.
• 5.In epidemic prone area Malaria surveillance should be based on weekly reporting.
• Prompt and effective malaria treatment for both acute and chronic cases.
• Questioning blood donors carefully.
• Personal Protective Measures:
• 1.Measures to reduce the risk of mosquito bites:• Avoid going out at night .
• Using insect repellents to exposed skin.
• Staying inside well constructed and maintained building.
• Using screen over doors ,windows and beds.
• Using anti mosquito sprays or insecticides dispensers.
• 2.Information of those at risk to mosquito exposure.
• Risk of getting malaria is variable between countries and regions.• Pregnant and children are risky for sever disease.
• It is a life threatening disease.
• May be with mild symptoms.
3.Advice for pregnant and parents of young children.
Chloroquine 5mg/kg/week and proguanil 3mg/kg/dayor Mefloquine 5mg/kg/week.
4.Advice persons traveling to endemic area to prepare stand by treatment.
5.Prophylaxis.
• Control of patients, contacts, and immediate environment:• 1.Report to local health authority.
• 2.Patient isolation in mosquito proof areas and with blood precautions for hospitalized patients.
• 3.Invistigate contacts and source of infection:
• History of previous infection or possible exposure.
• History of needle sharing.
• Blood donors investigation.
• 4.Specific treatment
• Chloroquine 25 mg/kg over 3 days .• (15 mg/kg in 1st day orally, 5mg/kg in the 2nd and 3rd day)
• b. For emergency parental quinine dihydrochloride20mg/kg. After 8 hours 10mg/kg.
• 8 hours later lower maintenance dose
Schistosomiasis (Bilharziasis)
Schistosomiasis (also known as bilharzia, bilharziosis or snail fever) is a parasitic disease caused by several species of trematodes (platyhelminth infection, or "flukes"), a parasitic worm of the genus Schistosoma.Schistosomiasis (Bilharziasis)
A blood fluke ( trematode ) infection with adult male and female worms living within mesenteric or vesicle veins of the host over a life span of many years.
Above all, schistosomiasis is a chronic disease. Many infections are subclinically symptomatic, with mild anemia and malnutrition being common in endemic areas. Continuing infection may cause granulomatous reactions and fibrosis in the affected organs, every organ of the body may be affected.
Symptoms are related to the number and location of eggs in human host
I. Schistosoma haematobium urinary manifestation (dysuria, urinary frequency and haematuria at the end of micturation).
II. Schistosoma mansoni and japonicum hepatic and intestinal signs and symptoms (diarrhea, abdominal pain, and hepatosplenomegally).
*Complications of chronic infection:
I. Obstructive uropathy, UTI, infertility and carcinoma of bladder .II. Liver fibrosis, portal hypertension, and colorectal carcinoma.
Acute schistosomiasis (Katayama's fever) may occur weeks after the initial infection, especially by S. mansoni and S. japonicum. Manifestations include:Abdominal pain, Cough, Diarrhea, Eosinophilia — extremely high eosinophil granulocyte (white blood cell) count. Fever, Fatigue ,Hepatosplenomegaly & Skin symptom.
Diagnosis:-
1.Demonstration of eggs in urine or stool or biopsy.2.Immunologic tests which indicate prior infection but not prove a current one.
Infectious agents:
Schistosoma mansoni :Schistosoma haematobium
Schistosoma japoncum
Major species causing
disease in man
• Occurrence :
• Schistosoma mansoni found mainly in Africa, Arabian area, and south America.• Schistosoma haematobium found in Africa and Middle East .
• Schistosoma japanocum found in China, Taiwan, and Indonesia.
Reservoir:
1.Human is the principal reservoir for Schistosoma haematobium, and mansoni.2.Dogs, cats, cattle, horses and wild rodents are potential reservoirs for Schistosoma japanocum.
intermediate host:
Snail species are :-1.Biomphalaria for Schistosoma manosni.
2.Bulinus for Schistosoma haematobium .
3.Oncomelania for Schistosoma japanocum.Mode of transmission :
Infection is acquired during working or swimming in water containing free swimming larvae (cercariae) that have developed in snails.
Eggs (in stool or urine) miracidia (in water) cercariae (in snail) through skin of man.
Blood vesselsof lung
Migrate to liver to
become mature
Migrate to abdominal
cavity veins
Note :-
It is important that appropriate snail presence ;as intermediate host. eggs, which, escaping through the stools or the urine, reach the water and liberate the Miracidium, this form swims freely in all directions seeking a specific snail, which it must find within eight hours or it will dieIncubation period :
Acute systemic manifestation may occur in primary infections (2-6) weeks after exposure.Period of communicability :
*No person to person transmission .
*Chronic schistosomiasis may spread eggs in urine and/or feces into water for as long as 10 years.
*Infected snails release cercariae for several weeks–3 months.
• Susceptibility and resistance :
• Susceptibility is universal.• Preventive measures:
• 1.Public education in endemic areas.
• 2.Hygenic disposal of urine and feces.
• 3.Improve irrigation and agriculture practices.
• 4.Using molluscicides for snail breeding sites .
• 5.Prevent exposure to contaminated water. (Use rubber boot).
6.Safe water supply for all purposes.
7.Treating patients in endemic areas by praziquantel.8.Advising travelers to endemic areas about risk and methods of prevention.
Control Measures :
1.Reports to local health authority.2.Sanitary disposal of urine and feces.
3.Investigation of contacts and source of infection.
4.Specific treatment (Praziquantel).